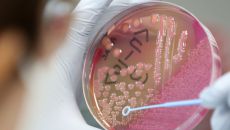

이슈뉴스
-

“더운 시간대 피하세요”…무더위에 온열질환자 하루 100명
무더위가 이어지면서 지난해보다 한 달가량 이른 시점에 하루 100명의 온열질환자가 발생해 각별한 주의가 요구된다. 3일 질병관- 2025.07.03 20:04
- 매일경제
-

'라돈 침대' 소비자에 손해배상 확정…7년 만에 대법 결론
[앵커] 매트리스에서 발암물질이 검출돼 이른바 '라돈 침대'로 불린 대진침대가 소비자들에게 위자료를 지급해야 한다는 판결이 대- 2025.07.03 19:06
- 연합뉴스TV
-

외식창업 수강생 25명, 포항 식당서 현장교육…대구시-영진전문대 공동운영
대구시와 영진전문대학교(총장 최재영)가 공동 운영하는 '외식창업 키워드림 아카데미'가 실전 외식 창업 교육의 일환으로 포항에서- 2025.07.03 19:02
- 아시아경제
-

대법 “라돈 검출 대진침대, 소비자에 위자료 지급해야”
이른바 ‘라돈 침대’ 논란이 불거진 지 7년 만에 제조사가 소비자들에게 위자료를 지급해야 한다는 판결이 처음으로 확정됐다. 대- 2025.07.03 19:00
- 세계일보
-

경북 포항에 식품로봇센터 들어선다...美위생협회와 업무협약
경북 포항시에 식품 개발에 로봇 기술을 접목하는 연구 지원센터가 들어선다. 3일 포항시 등에 따르면 이날 북구 흥해읍 포항융합- 2025.07.03 18:27
- 조선일보
-

“세계 1위 키트루다 이을 혁신신약 후보들 줄줄이 대기중”
조지 아도나 MSD 수석부사장 인터뷰 먹는 폐암·췌장암 치료제 ‘MK-1084’ 먹는 콜레스테롤 억제제 ‘엔리시타이드’ 알테오- 2025.07.03 18:10
- 매일경제
-

[르포] 불볕더위 속 국내 최대 석유화학공장 짓는 산업 역군들
(울산=연합뉴스) 장지현 기자 = "눈앞에서는 1천200도 불꽃이 튀고 바닥에서는 지열이 올라오죠. 모든 에너지를 다해 일하고- 2025.07.03 17:59
- 연합뉴스
-
대법 "라돈침대 제조사, 위자료 지급해야"
발암 물질인 라돈이 검출된 매트리스 제조사 대진침대가 소비자에게 위자료 지급 등 손해배상을 해야 한다는 대법원 첫 확정 판결이 나왔다. 3일 법조계에 따- 2025.07.03 17:58
- 매일경제
-

"서울도심 속의 알뜰 피서지"··· 관악구, ‘별빛내린천 어린이 물놀이장' 개장
서울 관악구는 ‘별빛내린천 어린이 물놀이장’을 개장했다고 3일 밝혔다. 물놀이장에는 아이들이 물줄기를 맞으며 더위를 식힐 수- 2025.07.03 17:55
- 서울경제
-

경기도의료원, 감염병재난대응단 공식 출범
경기도의료원(원장 이필수)은 3일 경기도의료원 안성병원 대강당에서 '감염병재난대응단 선포식'을 개최하고, 감염병 위기 상황에- 2025.07.03 17:25
- 아주경제
-

무더위 기승에 온열질환자 하루 100명…사망자 2명 더 늘어
(서울=연합뉴스) 성서호 기자 = 무더위가 기승을 부리면서 작년보다 한 달가량 이른 시점에 하루 100명의 온열질환자가 발생했- 2025.07.03 17:10
- 연합뉴스
-
울산 북구, 착한가격업소 37개소에 맞춤형 인센티브 지원
울산 북구는 착한가격업소 활성화를 위해 5월 31일까지 지정된 37개 착한가격업소에 인센티브를 지원했다고 3일 밝혔다. 북구는 지난 3월 착한가격업소 일- 2025.07.03 16:48
- 연합뉴스
-

감기약 먹고 운전해도 처벌?…이경규 사건으로 불붙은 '모호한 기준'
약을 먹고 운전한 혐의를 받는 방송인 이경규(65)가 검찰에 넘겨지면서 '약물 운전' 논의가 활발해지고 있다. 문제가 되는 약- 2025.07.03 16:33
- 머니투데이
-

군산시, 선유도해수욕장 9일 개장 앞두고 사전 점검실시
고군산군도 대표 해수욕장인 선유도해수욕장의 개장을 앞두고 군산시와 군산경찰서가 3일 합동점검에 나섰다. 이번 점검에는 군산시- 2025.07.03 16:29
- 연합뉴스
-

고등학생 35명 설사·복통 ‘집단 식중독’ 의심 증상…인천시, 역학 조사 착수
인천의 한 고등학교에서 학생들이 ‘집단 식중독’ 의심 증상을 보여 인천시가 사태 파악에 나섰다. 3일 인천시에 따르면 시는 지- 2025.07.03 16:28
- 매일경제
-
[인사] 시흥시
◇4급 승진 △문화체육관광국장 김태우 △환경국장 양순필 ◇4급 전보 △기획조정실장 이덕환 △대야동장 엄계용 △시흥시의회 고미경 ◇5급 승진 △소상공인과장- 2025.07.03 16:23
- 더팩트
-
[인사]시흥시
<4급 승진> ▲문화체육관광국장 김태우 ▲환경국장 양순필 <4급 전보> ▲기획조정실장 이덕환 ▲대야동장 엄계용 ▲시의회 고미경 <5급 승진> ▲소상공인과- 2025.07.03 16:08
- 아시아경제
-

물에 젖으면 떨어지는 러브버그…소방 살수차도 방제작업 투입
(서울=연합뉴스) 윤보람 기자 = "나뭇잎에 붙어서 쉬는 러브버그 성충을 젖은 채로 땅으로 떨어뜨려 죽게 하는 작업입니다. 소- 2025.07.03 16:05
- 연합뉴스
-

에베레스트에 쌓인 쓰레기 더미, 中 대형 드론으로 수거 중
(자카르타=연합뉴스) 박의래 특파원 = 산악인들이 수십 년간 버린 쓰레기로 몸살을 앓고 있는 세계 최고봉 에베레스트(해발 8천- 2025.07.03 16:04
- 연합뉴스
-

李대통령 “의정갈등 대화로 해결…전 정부 일방 강행에 문제 악화”
이재명 대통령이 3일 ‘신뢰 회복·대화·적절한 타협’으로 의정갈등을 풀겠다는 의지를 밝히자, 대한의사협회(의협)는 “의료시스템- 2025.07.03 16:02
- 서울신문
-

전국 최초 식품로봇 푸드테크 연구지원센터, 경북 포항에 착공
전국 최초로 경북 포항에 식품로봇 푸드테크 연구지원센터가 들어선다. 포항시는 3일 북구 흥해읍 포항융합기술산업지구에서 ‘식품로- 2025.07.03 15:55
- 아주경제
-

고리원자력본부 기장군 어린이집 55곳 제습기 지원
영·유아 호흡기 건강 알레르기 예방 도움 기대 한국수력원자력 고리원자력본부가 영·유아의 쾌적한 보육환경 조성을 위해 기장군 내- 2025.07.03 15:53
- 머니투데이
-
강남구, 2025년도 제1회 추경 705억원 확정
[한겨레] 강남구(구청장 조성명)가 편성한 2025년도 제1회 추가경정예산이 지난달 25일 최종 확정됐다. 이번 추경 규모는 일반회계 658억원, 특별회- 2025.07.03 15:50
- 한겨레
-

전국 최초 푸드테크 연구지원센터 포항에 착공… K-푸드 세계화 전진기지
포항시가 정부가 선정한 푸드테크 10대 핵심기술의 하나인 식품 로봇 기술 개발 메카로 거듭난다. 시는 3일 북구 흥해읍 포항융- 2025.07.03 15:50
- 아시아경제
-
인천 모 고교 학생 36명, 식중독 의심 증상
인천의 한 고등학교에서 학생 30여 명이 식중독 증상을 호소해 인천시가 역학조사에 나섰다. 3일 인천시에 따르면 전날 오후 3- 2025.07.03 15:42
- 조선일보

